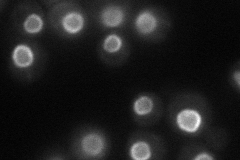
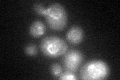
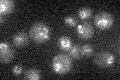

View description
Ubl (ubiquitin-like protein)-specific protease that cleaves Smt3p protein conjugates; specifically required for cell cycle progression; associates with nucleoporins and may interact with septin rings during telophase
Localization:
Intensity:
Fold change:
Significance:
-
C’ GFP library in SD

nuclear periphery21.14 -
N' NOP1pr-GFP in SD
nuclear periphery56.3136 -
N' TEF2pr-mCherry in SD

punctate,nuclear periphery0 -
N' NATIVEpr-GFP in SD

punctate,nuclear periphery25.6421 -
N' TEF2pr-VC and Cyto-VN in SD

#N/A0 -
C’ GFP library in SD+DTT
nuclear periphery21.861.03No -
C’ GFP library in SD+H2O2

nuclear periphery20.950.99No -
C’ GFP library in Starvation Media
nuclear periphery18.830.89No -
C’ GFP library on the background of Pup2-DaMP

nuclear periphery -
C’ GFP library on the background of CCT mutant

nuclear periphery23.80791.12592No
